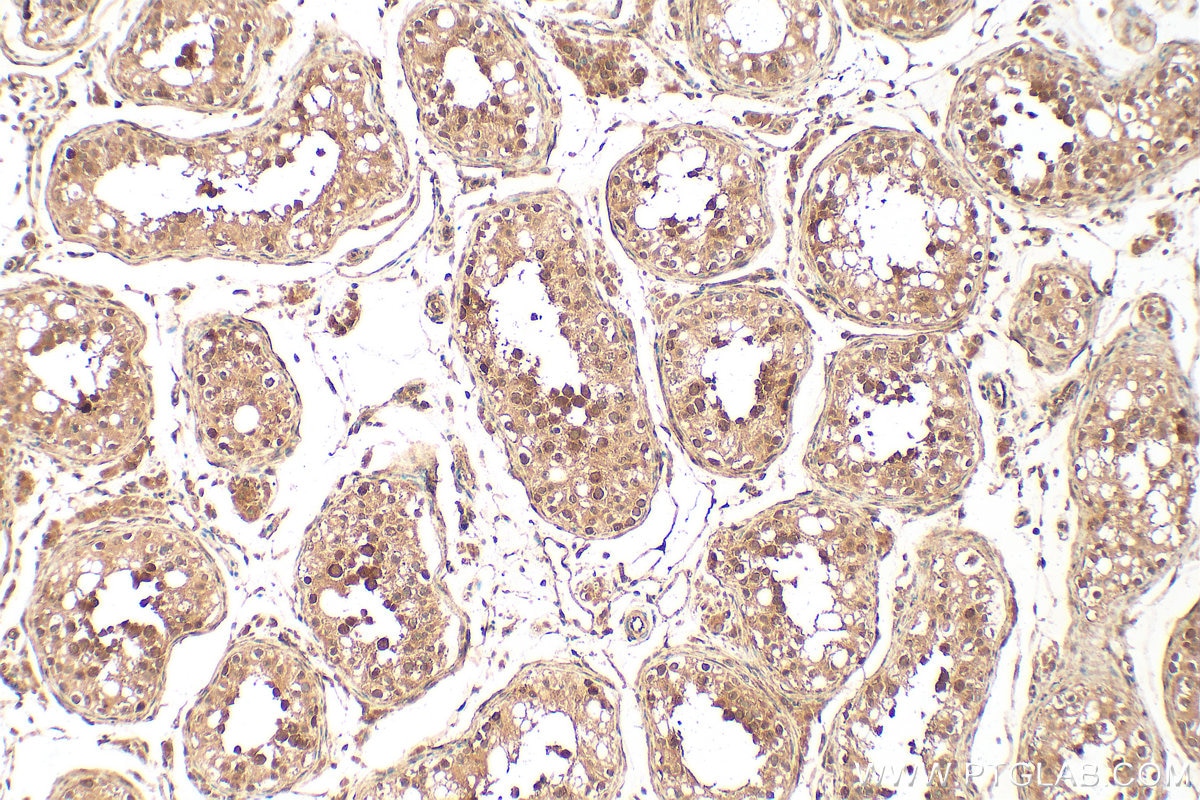
Immunohistochemistry (IHC) staining of human testis tissue using LIAT1 Polyclonal antibody (31796-1-AP)

Tested Applications
| Positive WB detected in | HEK-293T cells, HeLa cells, mouse kidney tissue, mouse liver tissue, mouse lung tissue, mouse spleen tissue |
| Positive IHC detected in | human testis tissue Note: suggested antigen retrieval with TE buffer pH 9.0; (*) Alternatively, antigen retrieval may be performed with citrate buffer pH 6.0 |
| Positive IF/ICC detected in | HEK-293 cells |
Recommended dilution
| Application | Dilution |
|---|---|
| Western Blot (WB) | WB : 1:500-1:2000 |
| Immunohistochemistry (IHC) | IHC : 1:50-1:500 |
| Immunofluorescence (IF)/ICC | IF/ICC : 1:200-1:800 |
| It is recommended that this reagent should be titrated in each testing system to obtain optimal results. | |
| Sample-dependent, Check data in validation data gallery. | |
Product Information
31796-1-AP targets LIAT1 in WB, IHC, IF/ICC, ELISA applications and shows reactivity with human, mouse samples.
| Tested Reactivity | human, mouse |
| Host / Isotype | Rabbit / IgG |
| Class | Polyclonal |
| Type | Antibody |
| Immunogen |
CatNo: Ag37082 Product name: Recombinant human C17orf97 protein Source: e coli.-derived, PGEX-4T Tag: GST Domain: 100-200 aa of BC141806 Sequence: GDDKHLSQSLKSQPLSSSFHDILSPCKERGPKPEHRQSKVEKKHLPSDSSTVSLPDFAEIENLANRINESLRWDGILADPEAEKERIRIYKLNRRKRYRCL Predict reactive species |
| Full Name | chromosome 17 open reading frame 97 |
| Observed Molecular Weight | 20-70 kDa |
| GenBank Accession Number | BC141806 |
| Gene Symbol | C17orf97 |
| Gene ID (NCBI) | 400566 |
| RRID | AB_3670116 |
| Conjugate | Unconjugated |
| Form | Liquid |
| Purification Method | Antigen affinity Purification |
| UNIPROT ID | Q6ZQX7 |
| Storage Buffer | PBS with 0.02% sodium azide and 50% glycerol, pH 7.3. |
| Storage Conditions | Store at -20°C. Stable for one year after shipment. Aliquoting is unnecessary for -20oC storage. 20ul sizes contain 0.1% BSA. |
Background Information
Liat1 (Ligand of Ate1) is a protein of unknown function that was originally discovered through its interaction with arginyl tRNA protein transferase 1 (Ate1), a component of the Arg/N-degron pathway of protein degradation.Liat1 participates in Liquid-liquid phase separation (LLPS), a process which enables the temporal and spatial regulation of important cellular processes such as RNA metbolism, genome organization, DNA repair, and transcription regulation. Liat1 interacts with itself, which means Liat1 can assemble into different species in nucleus or cytosol. Our WB is consistent with Arva A et al (PMID: 33443146).
Protocols
| Product Specific Protocols | |
|---|---|
| IF protocol for LIAT1 antibody 31796-1-AP | Download protocol |
| IHC protocol for LIAT1 antibody 31796-1-AP | Download protocol |
| WB protocol for LIAT1 antibody 31796-1-AP | Download protocol |
| Standard Protocols | |
|---|---|
| Click here to view our Standard Protocols |